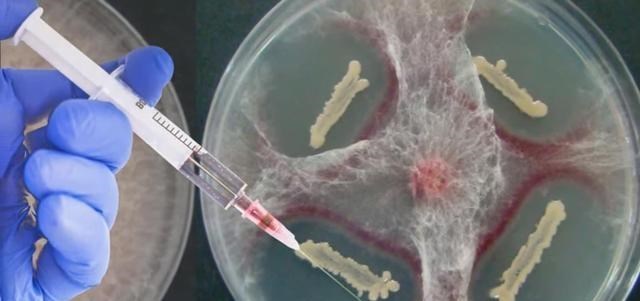
科学家 为了永生,科学家为自己注射350万年前的细菌,现在怎样了?

文章图片

文章图片
实现永生一直以来都是很多人的愿望 , 为了能够实现永生 , 在此之前的时候 , 很多人也都做了多次尝试 。
直到现代 , 一些科学家也并没有放弃对永生的研究 , 科学家们也非常希望通过一些技术来改变我们人类的寿命 , 就比如基因技术、身体器官更换等 。
甚至还出现了人体冷冻计划 , 而接下来的这名科学家为了能够找到永生的奥秘 , 甚至还为自己注射了350万年前的细菌 , 那么现在他怎么样了呢?
为了永生 , 科学家为自己注射350万年前的细菌 , 现在怎样了??
那么接下来我们就一起来了解一下究竟是怎么回事 , 来自莫斯科国立大学的阿纳托利博士在一次研究的过程中 。
从西伯利亚的一个山区多年冻土层中发现了一只被冰封的猛犸象 , 由于受到极寒等因素的影响 , 因此在刚刚挖掘出来的时候 , 这只猛犸象保留的非常完好 。
阿纳托利博士在继续研究中发现 , 在猛犸象的脑袋里竟然有一种细菌 , 这种细菌被命名为芽孢杆菌F 。
这种细菌非常神奇 , 就算是经过了350万年的冰封 , 在实验室中 , 它们依然很快的恢复了活性 。
阿纳托利博士则在这里面受到了启发 , 他表示 , 芽孢杆菌F可能存在着一种特殊的机制 , 能够让它在冰下存活很长时间 。
这种机制可能也可以运用在延长人类的寿命上 , 在受到了启发之后 , 阿纳托利博士就开始了自己的实验 , 在拿植物做实验后 。
他发现暴露于芽孢杆菌F的植物生长得更快 , 而且抗冻能力也比同类型的植物好一些 , 而且他还拿老鼠和果蝇进行了实验 。
通过结果发现 , 这种细菌可以让年老的雌性老鼠保持繁殖能力 , 而果蝇也受到了非常积极的影响 , 可见动物实验还是比较成功的 。
当看到一些实验结果后 , 阿纳托利博士也激动万分 , 最终他甚至还想到了将研究放在自己的身上 , 他决定给自己也注射芽孢杆菌F , 虽然这样做的风险非常大 。
但是他也并没有过多的犹豫 , 他表示自己毫不介意成为第一个实验芽孢杆菌F人 , 最终他也这么做了 , 虽说这样的做法是一件非常有风险的事情 。
但是好在他的身体并没有出现什么异样 , 但是在注射之后 , 他是否能够实现永生或者是延长寿命目前还是不得而知的 。
其实 , 一位名叫马努什·瓦斯奎兹的明星也注射了这一种芽孢杆菌F , 而这位明星在注射后 , 也谈到了自己的感受 。
她表示自己的状态非常好 , 感觉皮肤也变得更柔软了 , 而且也没有再得感冒了 , 不过这种细菌的效果究竟如何 , 是否能够起到延长寿命的作用 。
还是需要等待时间去研究的 , 尽管我们人类目前还无法实现永生 , 但是其实只要我们珍惜所过的每一天 , 人生的价值同样也会体现出来 。
把每一天都过的非常充实 , 不虚度年华 , 就算是不能永生 , 人生也同样会很精彩 , 也相信随着时间的推移 , 人们或许真的能够找到永生或者是延长寿命的秘密 。
【科学家|为了永生,科学家为自己注射350万年前的细菌,现在怎样了?】你觉得未来人类能够实现永生吗?欢迎下方评论留言!
推荐阅读
- 揭秘陶乐德事件:男子在拘留室离奇消失,难道平行时空真的存在?
- 青藏高原将停止增高,后果不可承受,我们却未感到危机
- 寻求气候变化的确定性:要多少才足够?
- 少见!今年十五的月亮,不是十六圆
- 科学家在大型强子对撞机上寻找难以捉摸的基本粒子
- 地球果真出了大问题?火山爆发后出现神秘现象,科学家紧急发声
- 简述相对论发展史:从伽利略到引力波
- 重磅!英美科学家对奥密克戎病毒11个最新判断!对全球意义重大!
- 15000年前海底金字塔被发现,科学家推测:中华文明前身是MU文明
- 人的气运竟然真的存在?科学家竟然已经证实!
